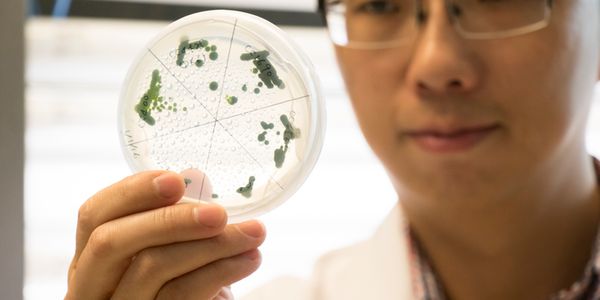

Showing 1571 Results
SEARCH
-
Image of an implantable cardioverter defibrillator. (Credit: Medtronic) In a recent study published in Heart Rhythm, an international team of resea
MAR 02, 2023
Chemistry & Physics
Image of argon plasma glowing a bluish color in an experiment at the WVU Center for KINETIC Plasma Physics. (Credit: WVU Photo/Brian Persinger) The
MAR 07, 2023
Neuroscience
Neuroscience examines the nervous system's and brain's functions, including diseases, disorders, and treatments. In this rapidly changing and expan
MAR 10, 2023
Chemistry & Physics
Illustration of intracluster bond formation, cluster containing two biomolecules, being exposed to UV light (left), causes a chemical bond forming betw
MAR 09, 2023
Earth & The Environment
Dr. Yantao Li with a microalgae sample. (Credit: University of Maryland Center for Environmental Science/Cheryl Nemazie) The US Department of Energy
MAR 06, 2023
Space & Astronomy
Ocean worlds are becoming a hot topic in the fields of planetary science and astrobiology, as Jupiter’s moon, Europa, and Saturn’s moon, Encela
Image of volcanic plume on Io from NASA's Galileo spacecraft taken in June 1997. (Credit: NASA/JPL-Caltech/ University of Arizona) Labroots prev
Saturn's moon, Iapetus, imaged by NASA's Cassini spacecraft in September 2007. (Credit: NASA/JPL-Caltech/Space Science Institute) We recentl